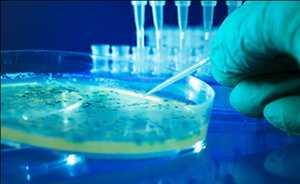
Global-E.-Coli-Testing-Market

El informe reciente de Mercado Resarch Store sobre Pruebas de E. Coli Mercado Report 2021 por Key Players, Types, Applications, Countries, Mercado Size, Forecast to 2027″ incluye un examen exhaustivo del panorama geográfico, el tamaño de la industria y la estimación de ingresos. Además, el informe destaca el desafíos que impiden el crecimiento del mercado, así como las estrategias de expansión utilizadas por las empresas líderes en el «Mercado Pruebas de E. Coli».
Ventajas clave para las partes interesadas
- El informe proporciona un análisis cuantitativo de las tendencias actuales del mercado Pruebas de E. Coli, las estimaciones y la dinámica del tamaño del mercado desde 2015 hasta 2028 para identificar las oportunidades predominantes.
- El análisis de las cinco fuerzas de Porter enfatiza la capacidad de los compradores y proveedores para tomar decisiones comerciales orientadas a las ganancias y fortalecer su red de proveedores y compradores.
- El análisis en profundidad, así como el tamaño y la segmentación del mercado, ayudan a determinar las oportunidades de mercado actuales de Pruebas de E. Coli.
- Los principales países de cada región se mapean en función de su contribución a los ingresos del mercado.
- El segmento de posicionamiento de los actores del mercado facilita la evaluación comparativa y proporciona una comprensión clara de la posición actual en el mercado de los actores del mercado de la industria Pruebas de E. Coli.
Competencia en el Mercado de Pruebas de E. Coli
El informe de mercado de Pruebas de E. Coli contiene información sobre los lanzamientos de productos, la sostenibilidad y las perspectivas de los principales proveedores, como: (Hologic, Danaher Corporation, Meridian Bioscience Inc, Novartis, Bio-Rad Laboratories, Dickinson and Company, Enzo Life Sciences Inc, Olympus Corporation, Johnson & Johnson, Abbott Laboratories)
Haga clic en el enlace para obtener una copia de muestra gratuita del informe @ www.marketresearchstore.com/sample/e-coli-testing-market-782456
Pruebas de E. Coli Mercado: Segmentación
Para el período 2021-2027, el mercado de Pruebas de E. Coli está segmentado por Tipo y Aplicación, y el crecimiento entre los segmentos proporciona artificios y pronósticos precisos para las ventas por Tipo y Aplicación en términos de volumen y valor. Este análisis puede ayudarlo a expandir su negocio al enfocarse en nichos de mercado calificados.
Pro tips
Anticuerpos Monoclonales, Diagnóstico Molecular, Inmunoensayo, Dispersión Diferencial de Luz, Otros
Por Aplicaciones
Tratamiento de Aguas Residuales, Hospitales y Centros de Diagnóstico, Laboratorios de Investigación, Otros
Mercado Pruebas de E. Coli: análisis regional
El mercado ha sido pronosticado durante todo el período de predicción, y toda la segmentación regional ha sido estudiada en función de las tendencias recientes y futuras. Los países cubiertos en el análisis regional del informe de mercado Global Pruebas de E. Coli son los
El mercado ha sido pronosticado durante todo el período de predicción, y toda la segmentación regional ha sido estudiada en función de las tendencias recientes y futuras. Los países cubiertos en el análisis regional del informe de mercado Global Pruebas de E. Coli son Estados Unidos, Canadá y México en América del Norte, Alemania, Francia, Reino Unido, Rusia, Italia, España, Turquía, Países Bajos, Suiza, Bélgica y el resto. de Europa en Europa, Singapur, Malasia, Australia, Tailandia, Indonesia, Filipinas, China, Japón, India, Corea del Sur y el resto de Asia-Pacífico (APAC) en Asia-Pacífico (APAC), Arabia Saudita, los Estados Árabes Unidos Emiratos, Sudáfrica, Egipto, Israel
Compra directa de este informe de investigación de mercado ahora @ www.marketresearchstore.com/market-insights/e-coli-testing-market-782456
Puntos principales cubiertos en TOC:
Descripción general del mercado: se divide en seis secciones: alcance de la investigación, fabricantes importantes cubiertos, fragmentos de mercado por tipo, segmentos de mercado de Pruebas de E. Coli por aplicación, objetivos de estudio y años considerados.
Panorama del mercado : en esta sección, la competencia en el mercado global Pruebas de E. Coli se analiza por valor, ingresos, ofertas y parte del pastel por organización, tasa de mercado, circunstancias competitivas Panorama y patrones más recientes, consolidación, desarrollo, adquisición y porciones de la industria general de las principales organizaciones.
Perfiles de los fabricantes: aquí se describen los principales actores en el mercado global Pruebas de E. Coli según la región del acuerdo, los elementos clave, la ventaja neta, los ingresos, el costo y la producción.
Estado del mercado y perspectivas por región: en esta sección, el informe examina la ventaja neta, las transacciones, los ingresos, la creación, la participación en la industria total, la CAGR y el tamaño del mercado por región. El mercado global Pruebas de E. Coli se examina a fondo en este informe en función de regiones y países como América del Norte, Europa, China, India, Japón y Oriente Medio y África.
Aplicación o usuario final: esta sección del estudio de investigación demuestra cómo las secciones excepcionales de aplicaciones/clientes finales contribuyen al mercado global de Pruebas de E. Coli.
Predicción del mercado: lado de la producción: los creadores se han centrado en la conjetura de la creación y la estimación de la creación, el indicador de los creadores clave y la estimación de la creación y la estimación de la creación por tipo en esta sección del informe.
Hallazgos y conclusión de la investigación: Esta es una de las secciones finales del informe donde se dan los descubrimientos de los investigadores y la conclusión del estudio de exploración.
¿Tiene alguna consulta o requerimiento específico? Pregunte a nuestro experto en la industria @ www.marketresearchstore.com/inquiry/e-coli-testing-market-782456
Preguntas clave respondidas en el informe:
- ¿Cuál será la tasa de crecimiento del mercado de Pruebas de E. Coli?
- ¿Cuáles son los factores principales que impulsan el mercado global de Pruebas de E. Coli?
- ¿Quiénes son los principales fabricantes del mercado?
- ¿Cuáles son las oportunidades, amenazas y estructura del mercado?
- ¿Cuáles son las ventas, los ingresos y el análisis de precios de los principales fabricantes en el mercado Pruebas de E. Coli?
- ¿Quiénes son los distribuidores, comerciantes y comerciantes del mercado Palabra clave123?
- ¿Cuáles son las oportunidades y amenazas de mercado de Pruebas de E. Coli a las que se enfrentan los proveedores de la industria global de Pruebas de E. Coli?
- ¿Qué es un análisis de mercado de ventas, ingresos y valor por tipos de mercado y aplicaciones?
- ¿Qué es un examen de trato, ingresos y valor por área de negocio?
Contáctenos:
Tienda de investigación de mercado
244 Quinta Avenida, Suite N202
Nueva York, 10001, Estados Unidos
Teléfono: +1 (844) 845-5245